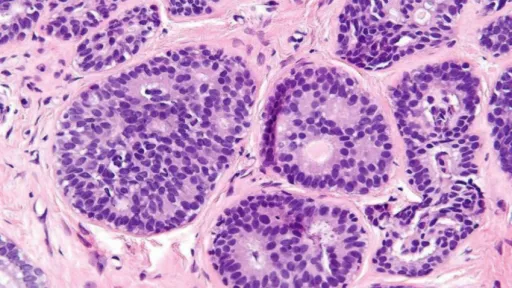

Un test revoluţionar pentru depistarea cancerului de sân a fost prezentat de cercetătorii germani. Este vorba despre o analiză de sânge care poate spune cu o precizie mare dacă boala şi-a făcut apariţia în organism.
Să nu uităm că în toate cazurile de cancer, diagnosticarea precoce este vitală pentru descoperirea bolii în stadiu incipient. Un astfel de stadiu presupune mari șanse de vindecare.„Avem acum un test de sânge care ne permite să aflăm dacă există un semn de boală sau dacă nu există un astfel de risc. În opinia mea, este un lucru pozitiv”, a declarat Christof Sohn, director medical la Spitalul Universitar Heidelberg, scrie digi24.ro.Testul va fi pus în vânzare în a doua parte a anului şi, spun cei care l-au creat, acesta nu îşi propune să concureze cu metodele deja clasice de diagnostic cum ar fi mamografiile sau RMN-ul.Potrivit Organizaţiei Mondiale a Sănătăţii, 2 milioane de noi cazuri de cancer de sân au fost diagnosticate anul trecut la nivel global şi peste 620.000 de femei au fost răpuse de această boală. Depistat în stadiu incipient, oamenii de ştiinţă spun că şansele de vindecare în cazul cancerului de sân sunt de 95%.